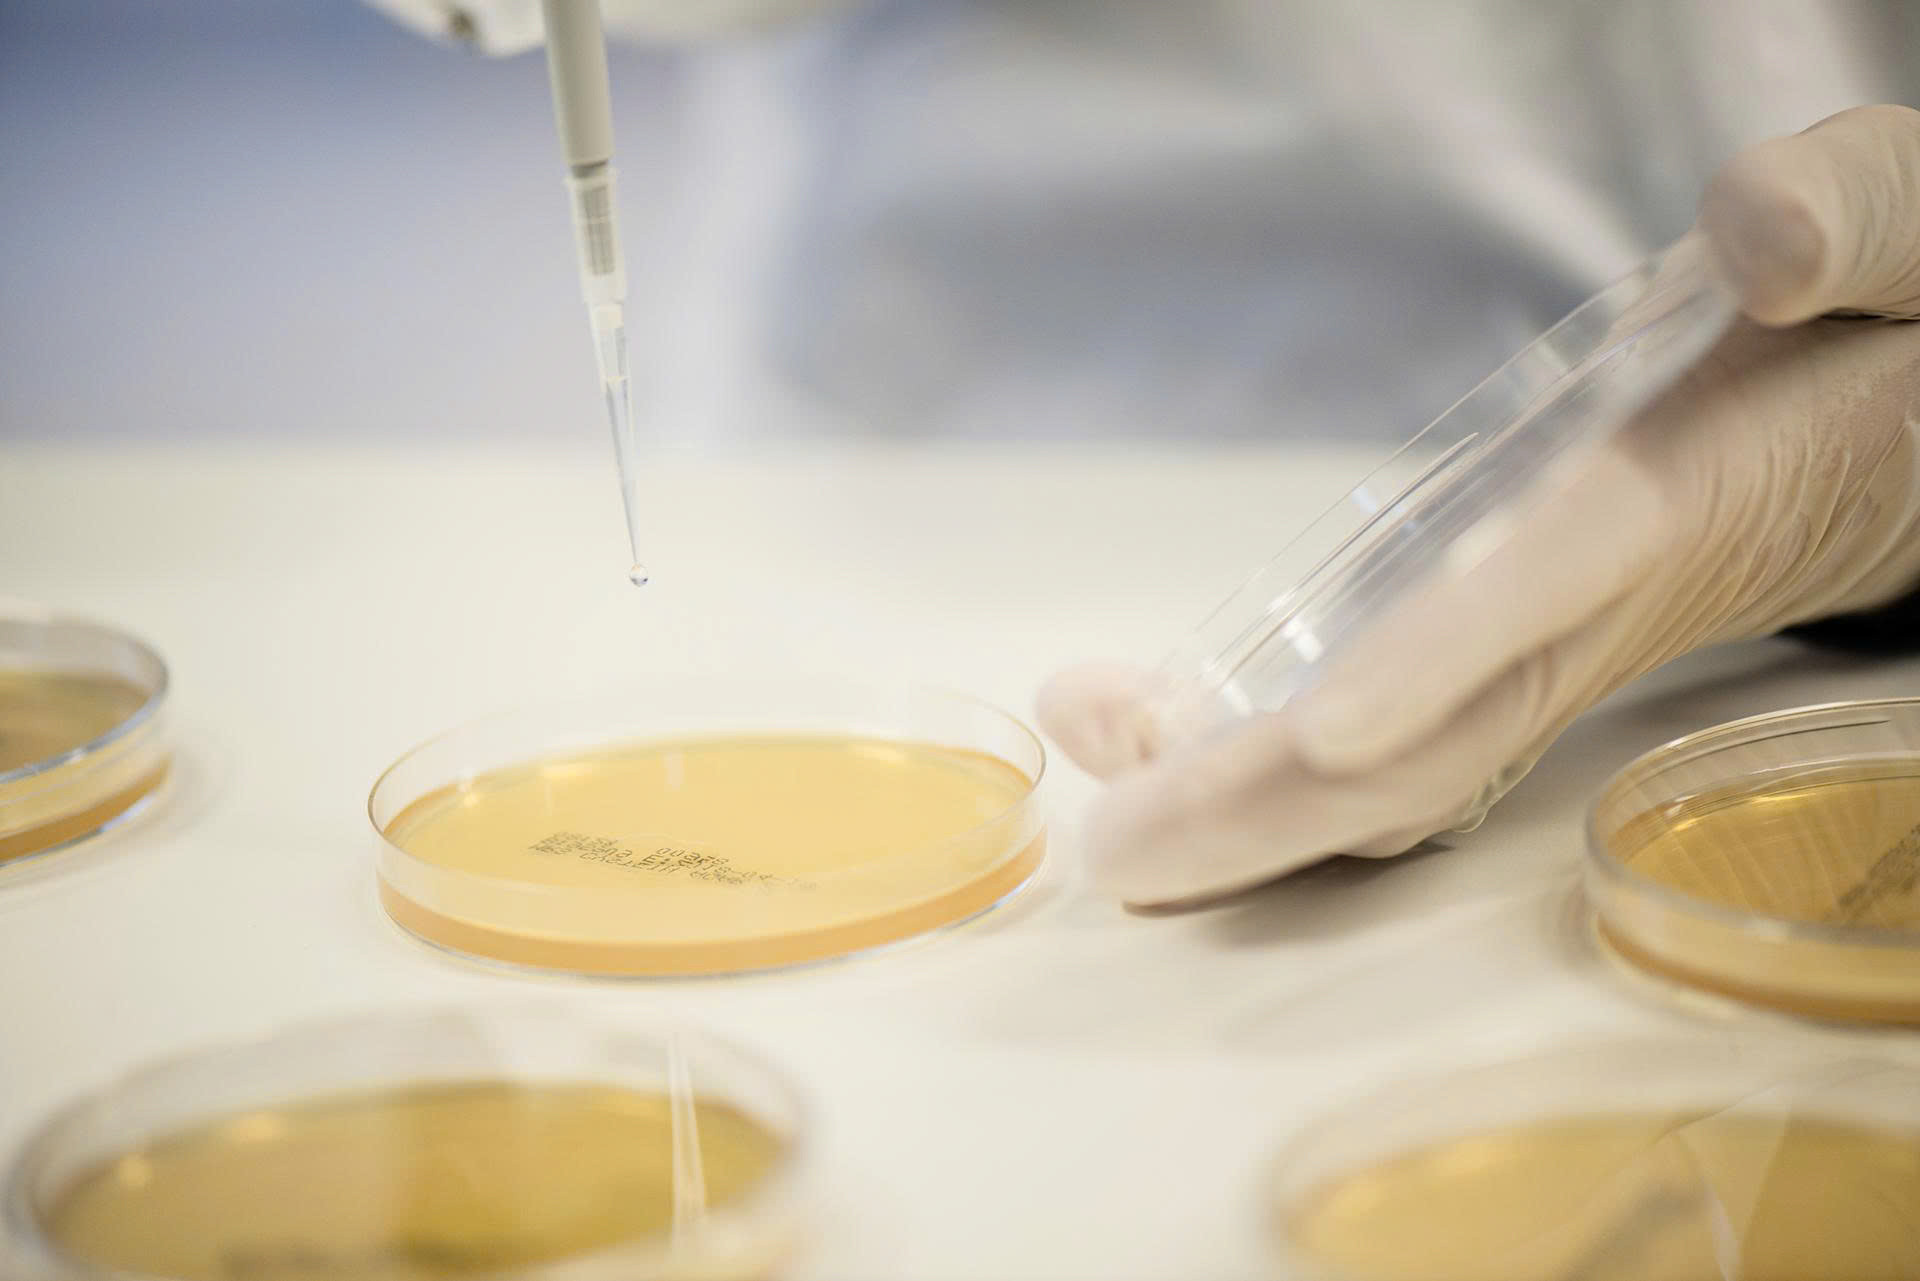
BioGaia Protectis3.jpg

Mùa cao điểm của bệnh tiêu hóa
Mùa hè cũng là mùa mà các vấn đề tiêu hóa lên ngôi. Khi di chuyển đến những vùng đất có quy trình vệ sinh hoặc khí hậu khác với những gì bạn đã từng ở nhà, hệ vi sinh vật đường ruột rất dễ bị mất cân bằng. Điều này dễ dẫn đến tiêu chảy du lịch, tình trạng phổ biến ảnh hưởng đến 20 - 50% du khách quốc tế mỗi năm.

Ngoài ra, những yếu tố như di chuyển dài trên máy bay, ăn uống thất thường, mất nước và lịch trình dày đặc có thể gây ra cảm giác đầy bụng, táo bón và mất ngủ, làm giảm đáng kể chất lượng trải nghiệm trong suốt chuyến đi.
Bên trong hệ tiêu hóa là một hệ vi sinh vật phức tạp, bao gồm hàng chục nghìn tỷ lợi khuẩn và hại khuẩn luôn cạnh tranh nhau. Khi hệ vi sinh này mất cân bằng, hại khuẩn sẽ dễ dàng tấn công, gây rối loạn tiêu hóa và suy giảm miễn dịch.
Không chỉ ảnh hưởng đến thể chất, hệ vi sinh vật đường ruột còn có mối liên hệ mật thiết với tâm trạng và giấc ngủ thông qua trục ruột - não (gut-brain axis). Khi vi sinh vật trong ruột mất cân bằng, hoạt động của các chất dẫn truyền thần kinh như Serotonin và Axit gamma-aminobutyric (GABA) cũng bị ảnh hưởng, khiến bạn dễ rơi vào trạng thái lo âu, mệt mỏi, mất ngủ khi đi xa.
Thực phẩm bảo vệ sức khoẻ BioGaia Protectis - ‘vệ sĩ’ đường ruột
Các nghiên cứu hiện đại đã chỉ ra rằng việc duy trì hệ vi sinh khỏe mạnh có thể hỗ trợ cải thiện tinh thần, giúp ngủ ngon hơn và giảm căng thẳng khi du lịch. Đó là lý do các chuyên gia khuyến nghị bổ sung men vi sinh trước và trong các chuyến đi xa, đặc biệt là những chủng đã được nghiên cứu lâm sàng như L.reuteri DSM 17938, có trong sản phẩm Thực phẩm bảo vệ sức khoẻ BioGaia Protectis đến từ Thụy Điển.

Để phù hợp với việc di chuyển liên tục của các chuyến đi, BioGaia cũng đã cho ra đời dòng sản phẩm Thực phẩm bảo vệ sức khỏe BioGaia Protectis Tablets - dạng viên nhai. Với dạng viên nhai tiện lợi, đóng hộp 10 viên nhỏ gọn, dễ dùng mỗi ngày, đây sẽ là người bạn đồng hành giúp bạn tận hưởng ẩm thực địa phương mà không lo rối loạn tiêu hóa quấy rầy; hỗ trợ tăng cường sức khoẻ hệ miễn dịch.
Sản phẩm này không phải là thuốc và không có tác dụng thay thế thuốc chữa bệnh. Tham khảo ý kiến chuyên gia y tế trước khi sử dụng.
Bích Đào